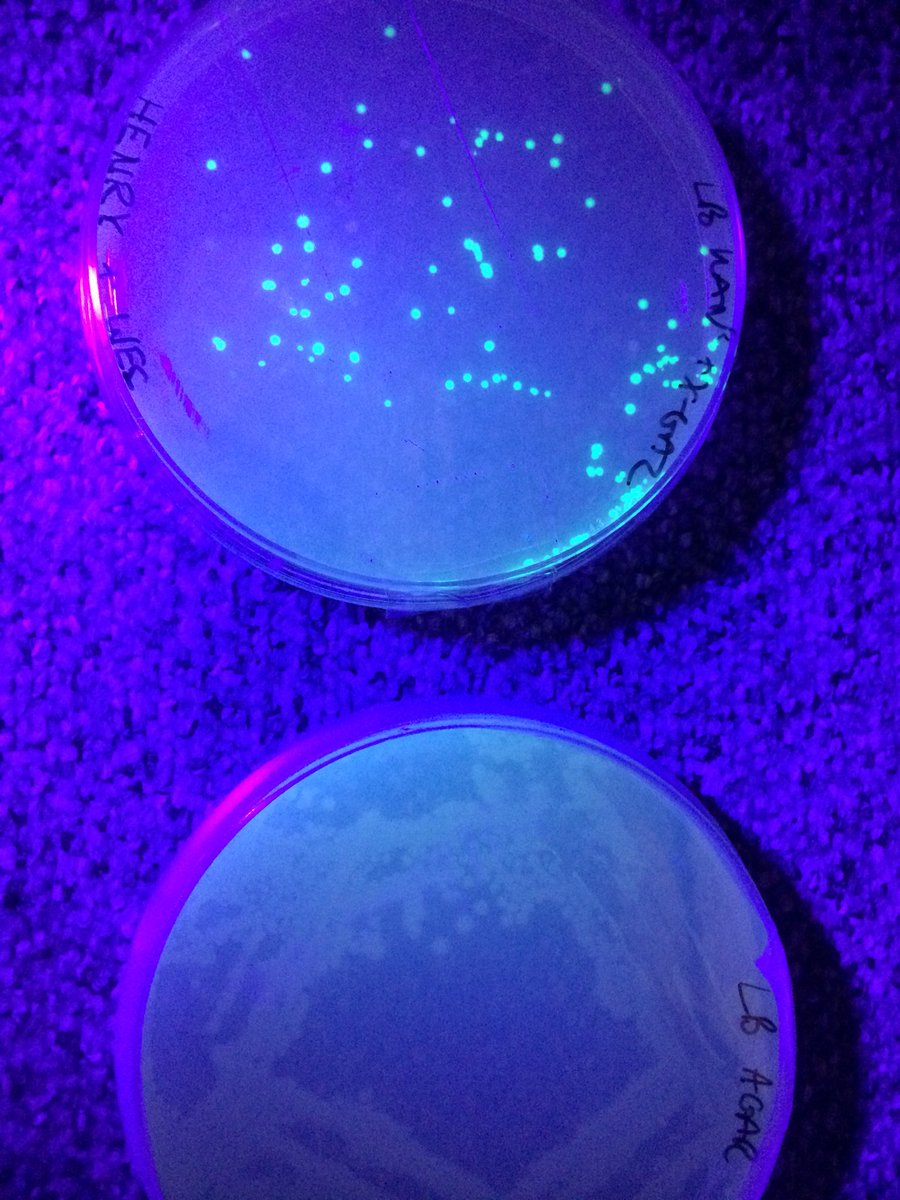
It worked! Genetically Modified bacteria (top) that glow under UV light while the originals (below) stay colourless.

Henry Williams
@hxnry_w
ID: 2853376012
31-10-2014 14:44:30
23 Tweet
17 Followers
79 Following









Retweet & barefootwine will give $1 to Surfrider Foundation #worldbeachrescueday for EVERY retweet! bit.ly/292azyS